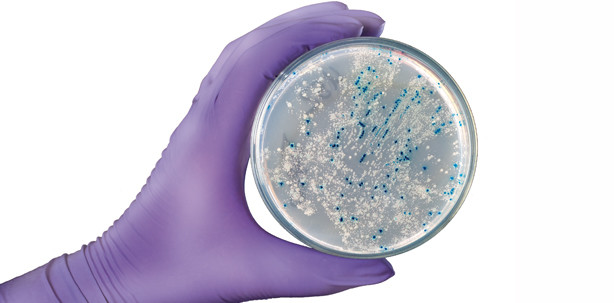
Parodontitis mit weitreichenden Folgen

Parodontologie 04.02.2014
Parodontitis mit weitreichenden Folgen
Dass die Parodontitis das Zahnfleisch zerstört und den Kieferknochen angreift, ist hinlänglich bekannt. Darüber hinaus wurde aber auch schon länger vermutet, dass die Parodontitis auch für die Arteriosklerose mitverantwortlich ist. Nun kamen Forscherteams der Universitäten Kiel (CAU), Schleswig-Holstein (UKSH), Bonn (FWU) und der Freien Universität Amsterdam der Ursache auf die Spur und konnten damit den evidenzbasierten Beweis durchführen.
Das RNA-Gen zur Behebung von DNA-Schäden, „ANRIL“ (Antisense Non-coding RNA in the INK4 Locus), wurde erst jüngst in einem bedeutenden Teil entschlüsselt. Es wurde als ein gemeinsames Risiko-Gen der Parodontitis und des Herzinfarktes enttarnt. Demnach scheinen die Entzündungsmediatoren der Parodontitis dieses Gen auszuschalten, was den Fettstoffwechsel verändert und nachfolgend zur Entstehung der Arteriosklerose als primäre Ursache des Herzinfarktes führt.
Entzündungsmediatoren der Parodontitis
Bei der Entschlüsselung des ANRIL-Gens waren Wissenschaftler imstande, die Genfunktion ab- und einzuschalten, um die Auswirkungen auf die menschliche Zelle zu beobachten. Dabei wurden weitere Risikovarianten entdeckt. Bei einem Defekt des ANRIL-Gens verändert sich auch der Zuckerstoffwechsel, was wiederum einhergeht mit der Entstehung von Diabetes mellitus, Bluthochdruck und Fettleibigkeit, aber auch chronisch entzündliche Darmerkrankungen hervorruft. Dem Funktionsausfall des ANRIL-Gens wird auch die Begünstigung der Entstehung diverser Krebsarten zugeschrieben; demnach zerstört die Zelle ganz spezifisch ihre eigene RNA, was nachfolgend zur Entartung der Zelle führt.
Weltweit größte Kollektivuntersuchung
Bei mehr als 21.000 Herzinfarktpatienten konnte man in der weltweit größten Kollektivuntersuchung des EuropeanPeriodontitis Genetics Consortium, publiziert im Oxford Journal „Human Molecular Genetics“, den Zusammenhang des Herzinfarktes mit dem Vorhandensein krankmachender Parodontalkeime nachweisen. Dabei war die Zielgruppe der Untersuchung – um die Unabhängigkeit der Befunde von anderen Krankheiten im höheren Alter zu gewährleisten – normalgewichtige Personen unter 35 Jahren, unabhängig von Geschlecht und Alter. Die Ergebnisse der Untersuchung zeigten unter anderem, dass der frühzeitigen Erkennung und entsprechenden Heilung von Parodontitis heute, in Anbetracht dessen, dass die Prävalenz der Parodontitis in den Altersgruppen jenseits des 30-Jährigen in Europa bei 80 Prozent liegt, zweifellos eine bedeutende Rolle zukommt.
Etablierte Therapiekonzepte
Das allgemeine Therapiekonzept bei Parodontitis lässt sich zunächst sehr einfach definieren: Es soll antiinfektiös therapiert, dabei sämtliche lokale Reize entfernt und die Keimbelastung auf ein Minimum reduziert werden. So simpel dieses Ziel erscheinen mag, es stellt eine nahezu unmöglich zu erfüllende Herausforderung dar. Die konservative Parodontitistherapie, deren Depuration mit eingeschränkten Instrumenten subgingival und ohne Sichtzugang erfolgt, entfernt nicht alle hartstofflichen Ablagerungen. Zudem kann es im Rahmen der Dekontaminationstherapie durch die Blutung zu einer Infiltration von oralpathogenen Keimen ins Gewebe kommen. Der Grund dafür sind die kaum zu vermeidenden mechanischen Verletzungen periparodontaler Weichgewebsstrukturen. Das seltener angewandte Behandlungskonzept der Full Mouth Disinfection (FMD) mit Chlorhexidin kann ebenso aufwendig wie patientenbelastend sein und kann zudem kontraindizierend wirken.

Abb. 1: Anschauliche Darstellung der Plasmawolke. – Abb. 2: Patientin mit FMT während der Full Mouth Disinfection.
Neues Therapiekonzept mit Plasma
Ein weiteres, neueres Therapiekonzept beinhaltet die Anwendung von Plasma (eine Wolke aus Atomen, Ionen und Elektronen). Dabei ist die antiinfektiöse Therapie, mit aus der Umweltluft gewonnenem kalten Plasma – abgekürzt CAP (cold atmospheric plasma) – simpel in der Anwendung. Nach der Depuration werden die oralpathogenen Keime im Mundraum, unter der Schutzatmosphäre eines doppelseitigen, weichen Mundapplikators (Full Mouth Tray – FMT), in nur wenigen Minuten durch die FMD mit Plasma beseitigt, ohne den Patienten dabei zu belasten. Selbst Keime in verbleibenden Konkrementen werden vom Plasma erreicht und eliminiert. Durch den atomaren Sauerstoff innerhalb des FMT kommt es zur Oxidation, d.h. zur Zerstörung einiger der anorganischen Stoffe, sodass die Konkremente weicher werden, bis nach mehrfacher Plasmatherapie die Konkremente sich mit der Zahnbürste entfernen lassen.

Abb. 3: OZONYTRON-XO – Abb. 4: OZONYTRON-XP/OZ
Behandlungsablauf mit Plasma
Speichel, Blut und Sulkus-Sekret werden abgesaugt. Das gasartige Plasma flutet dabei in die Unterdruckatmosphäre der Taschen, penetriert in die Mukosa bis tief in das Gewebe ein, utilisiert in Keime und desinfiziert dabei zielorientiert in nur wenigen Minuten. Die Zellmembranen der oralpathogenen Keime werden im Bruchteil von Sekunden zerstört, Resistenzen existieren nicht. Die Unterdruckatmosphäre wird dabei alternierend verändert, was zu einer tiefen Penetration des Plasmas in das Gewebe führt und gleichzeitig das Gewebe massiert. Der Wechsel der Unterdruckatmosphäre ist außerordentlich wichtig, um nicht nur die oralpathogenen Keime zu erreichen, die sich an der Gewebsoberfläche befinden, sondern auch jene Keime zu eliminieren, die tiefer im Gewebe sitzen. Der Patient hat im Anschluss einer Depuration, einer Chirurgie, einer Implantation etc. keine Nachblutung, keine Nachschmerzen und keine Schwellung im Gesicht. In der Regel werden auch keine Schmerzmitteln nach der Behandlung benötigt.
COP
Durch die Nutzung medizinisch reinen Sauerstoffs zur Plasmaumwandlung, kurz COP (cold oxygen plasma) genannt, wird gleichzeitig auch biologisch therapiert. Durch die mit COP zusätzlich erreichte Sauerstoffsättigung der Zelle wird der systemische Heilungsprozess beschleunigt.
Kontraindikationen
Unter Einsatz von COP sind unter der Schutzatmosphäre des Mundapplikators (FMT) keine Kontraindikationen angezeigt. „Niemand reagiert allergisch auf Sauerstoff“ – so verweist der ehemalige Charité-Parodontologe Prof. Dr. Hans-Georg Scheider in diesem Zusammenhang. Dasselbe gilt auch für CAP, gesetzt den Fall, die Umweltluft ist nicht smogbelastet. Bei stark smogbelasteten Luftverhältnissen beinhaltet die Plasmawolke auch Gase, welche als toxisch spezifiziert sind und den Heilungsprozess eventuell negativ beeinflussen können. In dieser Umgebung sollte man für die FMD COP anstatt CAP verwenden.
Erhaltungstherapie
Die therapeutische Relevanz der Erhaltungstherapie bei parodontal erkrankten Patienten ist elementar. Während der anfänglichen Therapie genügen in der Regel drei bis fünf Sitzungen bis zur Ausheilung. Wobei eine FMD nur wenige Minuten in Anspruch nimmt und delegierbar ist. Der erste Recall im Anschluss an die Therapie erfolgt nach drei Tagen, der zweite nach einer Woche, der dritte nach einem Monat; dann kann der Patient in der Regel in die halbjährliche Erhaltungstherapie mit der FMD-Plasmamedizin entlassen werden.
Geräte für die neue Plasmamedizin
Durch die Zusammenarbeit an der vom Bund geförderten Initiative Campus PlasmaMed der Universitäten Greifswald, Rostock, Wismar und Stralsund sowie Berlin, Göttingen, Homburg/Saar und München wurde ein Plasmastift entwickelt, welcher durch Mikroentladung der Raumluft punktuell Plasma-TtP (Tissue tolerable Plasma) erzeugt. Darüber hinaus befinden sich bereits praxiserprobte Geräte für die Plasmamedizin auf dem Markt. Zum Beispiel bietet das Unternehmen MIO Int. OZONYTRON mit der Gerätefamilie OZONYTRON zur FMD (Full Mouth Disinfection) mit CAP oder COP, zur Behandlung von Karies und Fisteln, zur Keimeliminierung und Förderung der Osseointegration in der Implantologie mit dem Zubehör für die direkte TtP-Medizin das multifunktionelle OZONY-TRON-XP/OZ und das OZONYTRON-XO an. Desweiteren sind die Geräte auch in der Dermatologie z.B. zur Therapie von diabetischer Gangrän am Fuß/Bein, zur Behandlung von Tumoren an der Hautoberfläche sowie für den Bereich der HNO-Medizin einsetzbar.